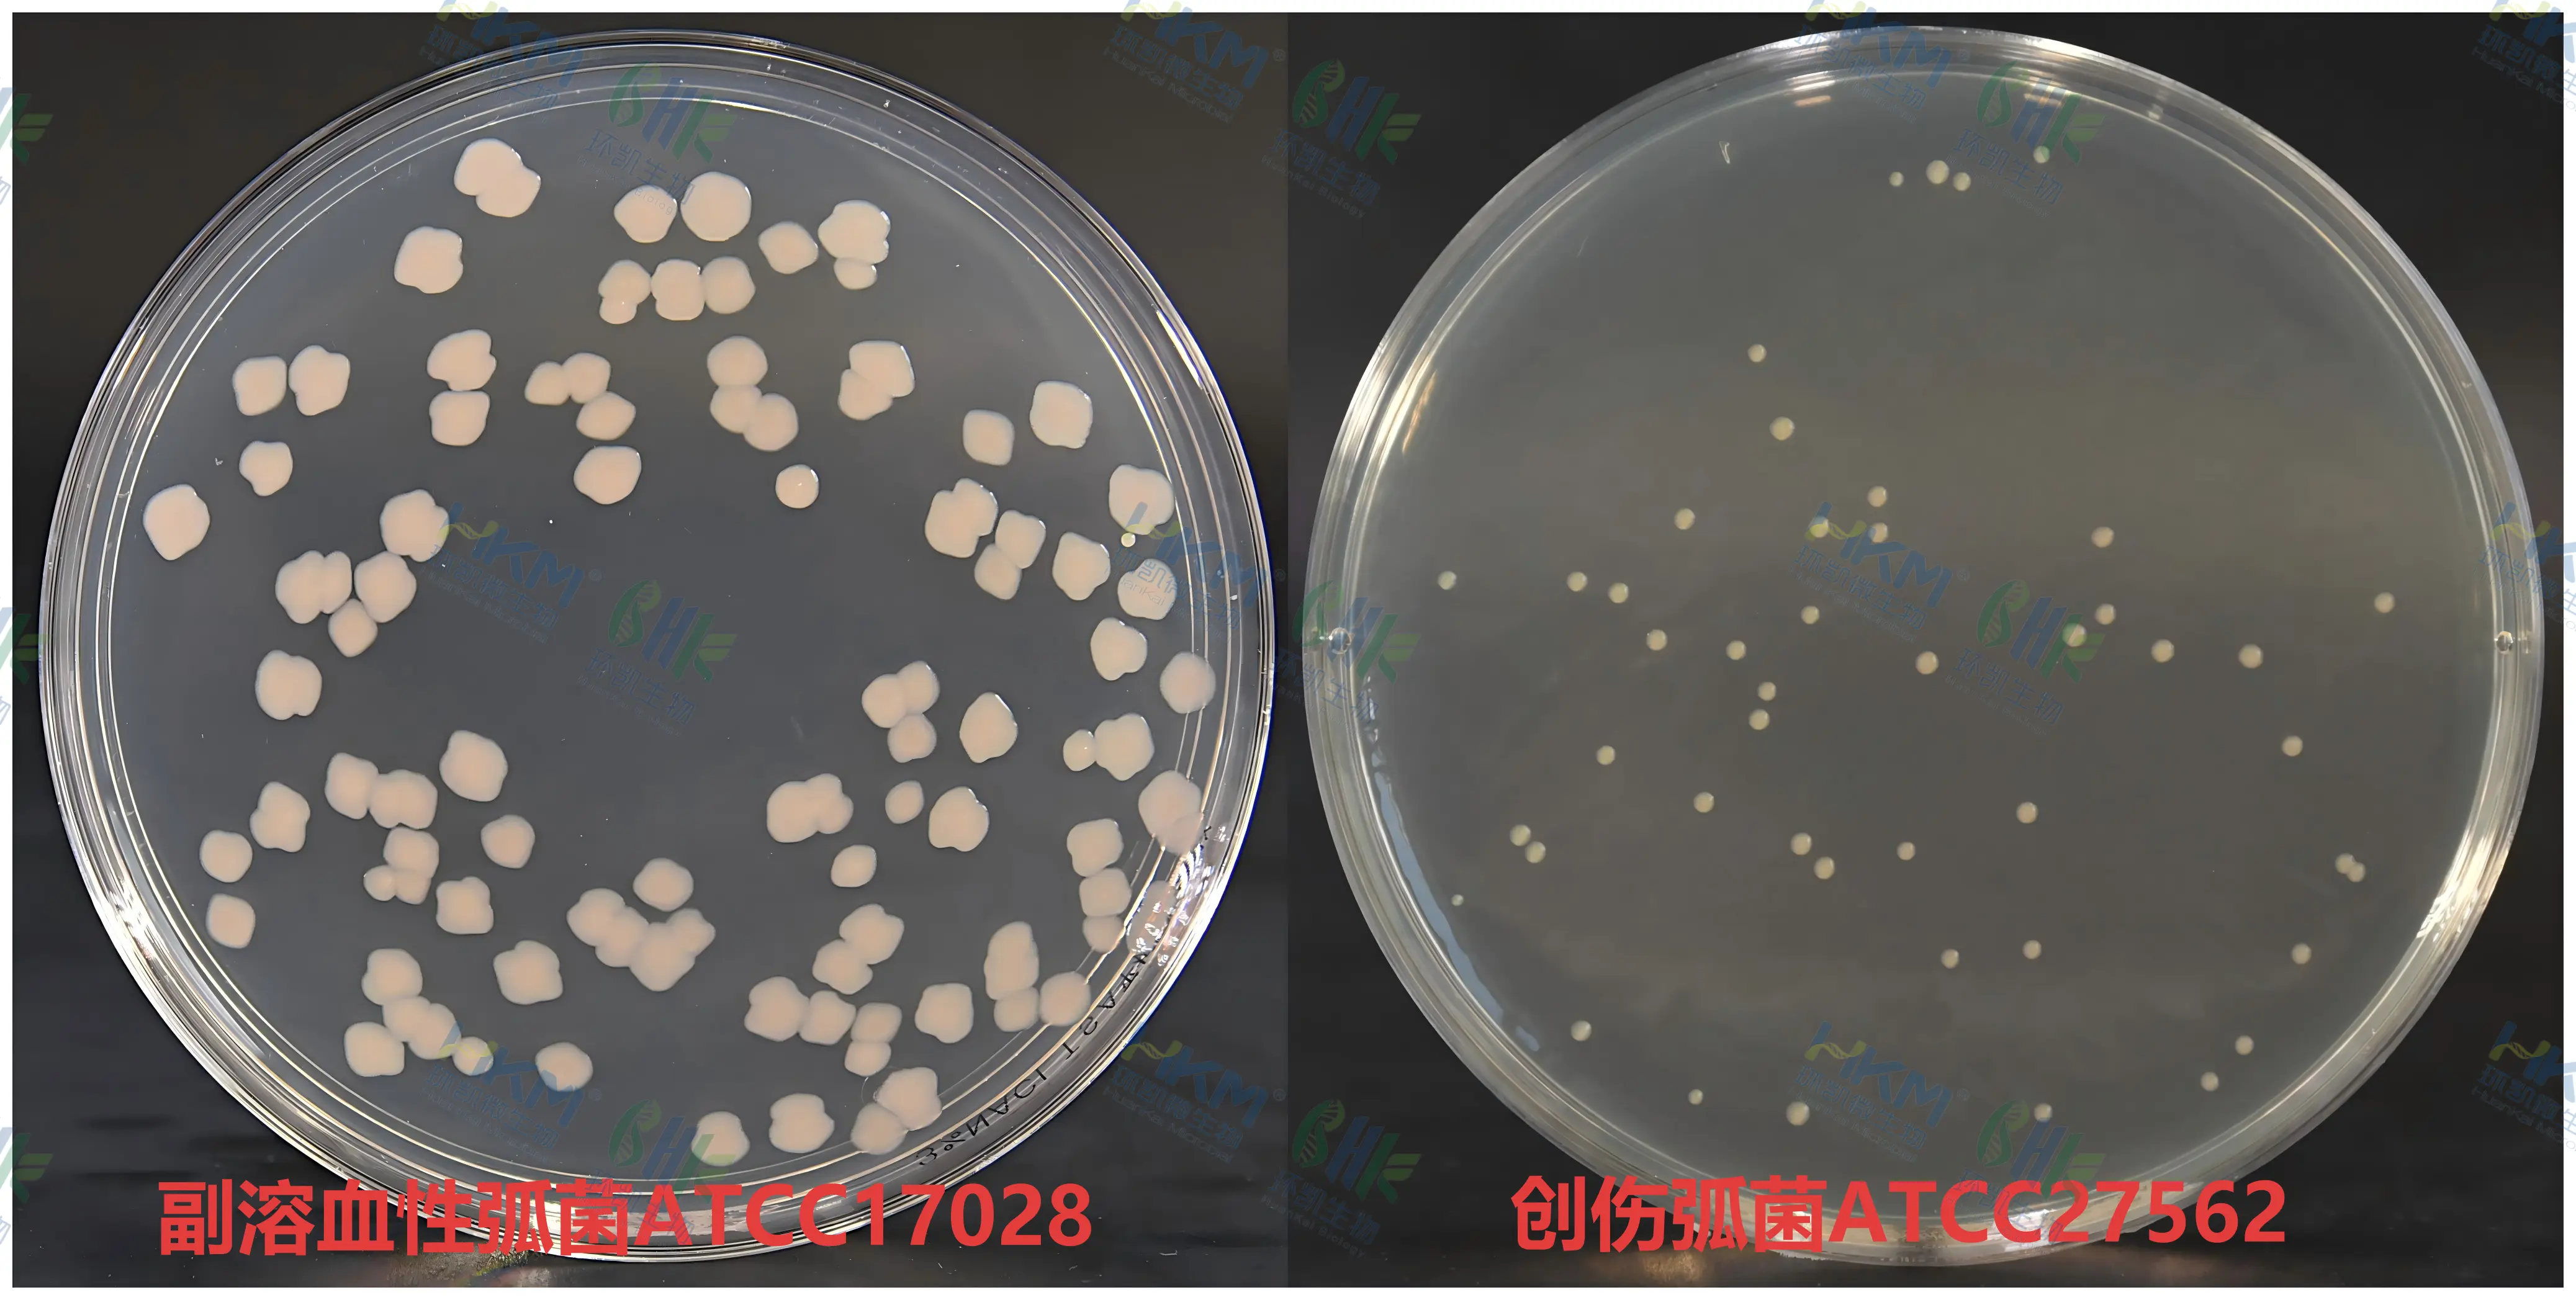
3％氯化钠胰蛋白胨大豆(TSA)琼脂质量控制

商品详细
说明书
微生物图册
行业应用
相关论文
产品名称:3%氯化钠胰蛋白胨大豆琼脂
英文名称:3%NACl Tryptic Soy Agar
其它叫法:3%氯化钠胰蛋白胨大豆(TSA)琼脂 | 3%氯化钠TSA琼脂培养基
产品编号与包装规格:
| 产品编号 | 产品类型 | 包装规格 |
|---|---|---|
| 025043 | 干粉 | 250g/瓶 |
产品用途:用于副溶血性弧菌的生长试验。
检验原理:胰蛋白胨、大豆蛋白胨提供氮源、维生素、生长因子; 高含量氯化钠可以抑制非弧菌类细菌生长,不影响副溶血性弧菌生长;琼脂为凝固剂。
3%氯化钠胰蛋白胨大豆(TSA)琼脂配方成分:
| 配方(每升) | 含量 |
|---|---|
| 胰蛋白胨 | 15.0g |
| 大豆蛋白胨 | 5.0g |
| 氯化钠 | 30.0g |
| 琼脂 | 15.0g |
| 最终pH 7.3±0.2 | |
使用方法:称取本品65g,溶于1L蒸馏水或去离子水,搅拌加热煮沸至完全溶解,分装三角瓶或试管,121℃高压灭菌15min,备用。
3%氯化钠胰蛋白胨大豆(TSA)琼脂质量控制【下列质控菌株接种后于36℃±1℃培养8h~18h,观察结果如下表:】:
| 指标 | 质控菌株及编号 | 方法 | 标准值 | 特征性反应 |
|---|---|---|---|---|
| 生长率 | 副溶血性弧菌CMCC(B)20033 或 ATCC 17028 | 定量 | PR≥0.7 | 无色半透明菌落 |
| 创伤弧菌CMCC(B)17244 或 ATCC 27562 |
储存条件与保质期:贮存于避光、干燥处,用后立即旋紧瓶盖;贮存期三年。
注意事项:干粉培养基使用后立即旋紧瓶盖,避免吸潮结块;开封后根据存放条件的不同保质时间存在一定的差异。
废物处理:检测之后带菌物品置于121℃下高压灭菌30分钟后处理。
参考文献:
1、GB 4789 .7-2013 食品安全国家标准 副溶血性弧菌检验
2、SN0173-92 中华人民共和国进出口商品检验行业标准 出口食品中副溶血性弧菌检验方法
3、SN0173-2010 中华人民共和国进出口商品检验行业标准 出口食品中副溶血性弧菌检验方法
